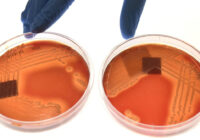

Superbugs Could Kill 40 Million People by 2050: A Looming Global Health Crisis
Drug-resistant infections, commonly referred to as “superbugs,” pose an increasing threat to global health. A new study published in The Lancet projects that by 2050, nearly 40 million people could die due to antimicrobial resistance (AMR), unless urgent actions are taken. The rise of drug-resistant pathogens is a growing concern, with experts warning that the… Read More: Superbugs Could Kill 40 Million People by 2050: A Looming… »